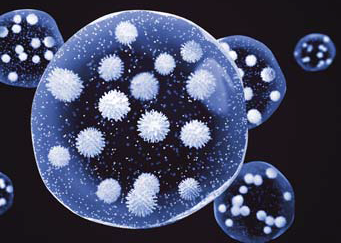

空氣濕度與健康
干燥空氣對人體的影響
人們能輕松辨別所處環境的冷熱,但空氣濕度的高低是無法明確感知的。對于我們所吸入肺部或與皮膚、身體相接觸的空氣含水量,我們做不到即刻的反饋。
然而,空氣濕度會對我們產生重大的影響,如果長時間處于極端環境中,可能會帶來損害。
干燥的空氣會從其接觸的任何來源中吸取水分,包括我們的身體。水分可從我們的眼睛、皮膚、頭發、指甲和任何其他體表蒸發。這種脫水最初可能會造成不適,如眼睛酸痛或隱形眼鏡刺激,但也可能會導致更嚴重的癥狀,如皮膚干燥、瘙癢以及皮炎。
更嚴重的是,這會影響我們的呼吸和免疫系統。當我們所呼吸的空氣相對濕度低于40%時,鼻子、喉嚨和支氣管中的黏膜會變得干燥,而這些要素在我們人體抵御經過空氣傳播的污染物(如病毒和細菌)時起著至關重要的作用。在經過空氣傳播的微粒進入我們的肺部之前,這些潮濕的黏膜會將這些微粒俘獲。被稱為纖毛的微小毛發將這些污染物運輸至我們的喉嚨部位,然后將其咳出或吞下并破壞。這一過程被稱為黏膜纖毛的清除過程。
當我們的黏膜變干時,這種天然防御機制將受到抑制,從而使我們更易于感染經過空氣傳播的病毒和細菌。
科學依據
多年來人們進行了大量的研究和調查,演示濕度如何會對人體產生影響。以下是這些研究的摘要總結,這些著名實例闡述了維持一個最佳的濕度值為身體健康及福祉帶來的受益。
研究:對較低相對濕度的生理和主觀反應
作者:Sunwoo Y等人,2006年
引用:體質人類學雜志,2006年1月;25(1):7-14
方法:在25℃和10%RH、30%RH和50%RH的受控條件中對16位健康的受試者進行監測。對受試者的體質情況進行監測,包括黏膜纖毛的清除時間、眨眼的頻率、皮膚的水合作用以及經表皮水分損失。還會要求受試者對溫度、干燥情況和舒適度感覺進行主觀判斷。
結果總結:如果相對濕度較低,則會對黏膜產生不利的影響,眼睛黏膜和皮膚角質層(外層)干燥會導致皮膚的平均溫度下降。有趣的是,當降低濕度之后,受試者會立即感覺到寒冷,但在干燥環境中卻沒有明顯的感覺。
研究:健康受試者吸入干燥空氣時,體內的鼻粘膜纖毛的運輸會減慢
作者:Salah B等人,1998年
引用:歐洲呼吸雜志,1988年10月;1(9):852-5
方法:評估吸入干燥空氣對鼻子清除作用的影響,在11位健康受試者中,在其鼻孔中沉淀250微克糖精,同時吸入干燥或室內空氣。每隔30秒吞一次口水,測定沉淀與第一次感覺到糖精味道之間的時間。
結果總結:吸入干燥空氣會導致鼻黏膜過度失水,反過來,由于流變學特性或鼻黏膜粘著性的變化以及/或纖毛拍打速度的減慢,從而會降低鼻子黏膜纖毛的清除作用。
研究:關于人類鼻子黏液流量的研究
作者:Ewert G,1965年
引用:耳鼻喉補編,1965;200:SUPPL 200:1-62
方法:粉末微粒插入受試者鼻孔之后,觀察微粒需要花多長時間移動2mm,從測定人類鼻子在不同濕度水平中的黏液流量。
結果總結:平均流量與環境空氣的相對濕度存在比較重大的相互關系。隨著濕度下降,在>70%RH時會出現最佳流量,并會持續減小。
研究:相對濕度對室內空氣質量的二分法
作者:Wolkoff P、Kjargaard SK,2007年
引用:國際環境,2007年8月;33(6):850-7. Epub 2007年5月17日
方法:對與相對濕度相關的各種流行病學、臨床和人體暴露研究進行檢查。
結果總結:這些研究表明,較低的相對濕度在增加所報告眼睛刺激癥狀以及改變角膜前淚液膜的過程中起著重要作用。在視覺顯示單元工作的過程中,這些影響可能會加劇。與低于30%的水平相比,40%左右的相對濕度對于眼睛和上部氣道會更好。
較低相對濕度對我們共享空氣的影響
對于分散和運行在建筑物周圍的病毒和需經空氣傳播的細菌來說,低于40%RH的較低濕度就猶如一條通道。這是因為在較低相對濕度中,病毒存活的時間得以延長、傳染性微粒在干燥空氣中的懸浮作用也得到增強,二者便更易結合。
當感染者呼吸、說話、咳嗽或打噴嚏時,他們會將氣溶膠性質的微霧釋放到空氣中,而這些微霧中含有眾多要素,包括唾液、黏液、鹽類、病菌和病毒。較大的霧滴會落到地上或停留在體表,但尺寸小于4μm的微霧——經過實驗證明——能以氣溶膠的形態在空氣中停留數小時。
在室內空氣中,通過蒸發作用所釋放出來的微霧會迅速失去90%以上的水分。在相對濕度值高于40%RH時,鹽類和蛋白質類的要素雖仍會溶解在微霧中,但易變得高度濃縮。它們會攻擊病毒和細菌,使其變得不活躍,以降低二次感染的風險。
然而,當低于40%RH的臨界水平時,蒸發性水分的進一步損失會造成這些要素在溶液外結晶。氣溶膠霧粒的內部環境從具有攻擊性變成了對內部病菌起到保護作用,這就使得其中的病毒和細菌能更長時間地保持傳染性。
較低濕度還會使更多霧粒蒸發,從而使其尺寸減小得以維持氣溶膠的形態。因此,干燥空氣便具有生成更多氣溶膠微粒和延長所攜帶病菌傳染性的雙重作用,大大提高了二次感染的潛在風險。
科學依據
多年來人們進行了大量的研究和調查,演示濕度如何對氣溶膠病菌(如感冒和流感病毒)傳播和存活率產生影響。以下是這些研究的摘要總結,這些著名實例闡述了維持一個最佳的濕度值對改善室內空氣質量和人類健康帶來的受益。
研究:較高濕度可損耗模擬咳嗽中的傳染性流感病毒
作者:Noti JD等人,2013年
引用:PLoS One.,2013年;8(2):e57485
方法:在相對濕度水平為7-73%的不同水平中,在室內用配有不同噴霧器的人體模特“咳出”流感病毒。用空氣采樣器收集懸浮氣霧微粒,以便了解其在不同室內條件中的持續傳染性。
結果總結:在較低的相對濕度中,流感病毒保留了最大傳染性。相對濕度高于40%RH時,病毒在咳出后迅速失活。將室內相對濕度維持在40%以上可顯著降低霧化病毒的傳染性。
檢測:人居環境中的最佳相對濕度
作者:Sterling EM等人,1985年
引用:ASHRAE Transactions,第91冊,第1部分,CH85-13 第1期,1985年
方法:回顧相關生物和化學相互作用的健康文獻,以便在可能會降低總體健康風險的地方確定最佳濕度范圍。對于生物污染物、導致呼吸問題的病原體以及它們間的相互化學作用,人們檢測到濕度在19-27oC的正常室內溫度中起作用。
結果總結:在正常室溫中,降低人類遭受生物污染物、病原體和化學相互作用風險的最佳濕度出現在40-60%RH的較窄范圍中。
研究:在室內經空氣傳播的A型流感動力學以及與濕度的相關性
作者: Yang W,Marr LC
引用: PLoS One.,2011年6月1日 | 第6冊 | 第6期 | e21481
方法: 在10-90%的相對濕度水平中,模擬從咳嗽中釋放出的、攜帶A型流感病毒(IAV)的氣溶膠尺寸、分布和轉變。
結果總結: 在IAV的氣溶膠傳播過程中,濕度為重要的變量,因為它會導致霧粒尺寸的變化,并影響IAV的失活率。病毒的失活率會隨著相對濕度呈線性上升趨勢;相對濕度最高時,失活作用可在10分鐘內去除高達28%的IAV。
研究:流感與濕度——為什么濕氣略高會使您受益?
作者:Jane A. Metz,Adam Finn
引用:感染學雜志(2015年)71,S54eS58
方法: 回顧1960年以來關于濕度和溫度的調查研究,并檢測其對流感病毒存活、傳播和傳染率的影響。
結果總結: 在不同的濕度水平中,對調查流感病毒存活情況的體外實驗進行數學建模。結果顯示,濕度較低時,流感病毒的存活率升高。通過提高托兒所、教室、醫院、養老院和一般公共空間的濕度,降低流感相關發病率的前景令人興奮,這也是使病毒失去攻擊性的潛在戰略。
——維持40-60%RH是抑制氣溶膠傳播感染的有效途徑。
關于濕度水平的成文規定
很多領導機構和專業組織出版了大量關于濕度水平的規定和推薦規范,大多數人同意健康的最佳水平為40-60%RH。
→ HSE:有關顯示屏設備的健康及安全(顯示屏設備)規定1992版由健康和安全(雜項修訂)修訂出版規定2002版
熱度和濕度(章節名)
35、電子設備可能是一種可在工作站中改變熱環境的干燥熱源,應將通風情況和濕度水平維持在可避免眼睛不適和眼睛酸痛問題的水平值。
? BSRIA:應用指南AG10.94.1建筑物中的有效加濕,1995年3月
熱量舒適度(章節名)
1.1 RH的極端情況為非理想情況,并會影響人類的舒適度、生產力和健康。因此,對于大多數應用場合來說,室內相對濕度不應超過60%、也不得低于40%。
健康(章節名)
1.4 較低濕度可能會影響居住者的健康。較低濕度通常會造成皮膚、鼻子、眼睛、喉嚨和黏膜干燥,而自始至終較高的濕度則可提供適于有害生物體生長的條件。
→ CIBSE:指南A,環境設計,第8版,2015年3月
1.3.1.3 設計空調系統時,在夏季設計運行溫度的推薦范圍內,60%的最大室內相對濕度會為人類居住者提供可接受的舒適度條件,并將霉菌生長的風險降至最低……
……如果可以,在通常適于久坐不動的居住者的設計溫度中,室內濕度應高于40%RH。較低濕度通常在短時間內是可接受的;≤30%RH的濕度可能是可接受的,但應采取預防措施,限制產生灰塵和經空氣傳播刺激物,并防止向居住者釋放靜電或防止居住者釋放靜電。當濕度高于40%RH時,不可能出現由于靜電產生的電擊;如果是較低的濕度,應檢查材料和設備是否采取了規范中防止靜電堆積的預防措施……
? ASHRAE:關于經空氣傳播傳染病的位置文件,19/01/2014,第14頁
ASHRAE建議:
新的保健設施(包括關鍵入口,如急診樓、住院樓、候診室的;擁擠的避難所以及類似設施)應與快速響應流行性疾病的基礎設施相結合。此類基礎設施需包括,例如……具備空氣加濕的能力......→ CIBSE:知識系列,KS19:加濕,2012年10月
健康和舒適度(章節名)
3.1.1 CIBSE建議,對于人類舒適度和健康來說,應將相對濕度維持在40%-70%之間,裝配空調的空間內,最大的正常濕度值應維持在60%RH。人們公認,在自然通風建筑物中,可在短時間內將濕度降至30%,與空調建筑物相比,自然通風建筑物必然會在更低的濕度中起作用。

如果鼻子和支氣管中的黏膜干燥,則會抑制體內的天然防御機制,這會使我們易于感染經空氣傳播的病毒,如流感和普通感冒

眼睛酸痛是長時間暴露于干燥環境中的癥狀之一

如果皮膚的上表皮層暴露于干燥空氣中,則會引發皮膚干燥,從而導致瘙癢、開裂和很多皮膚問題